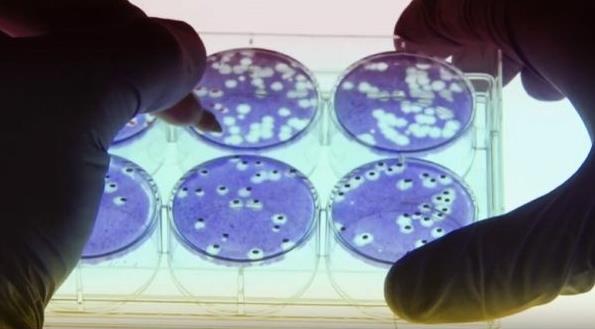

中国海军第40批护航编队特战分队——磨砺敢打必胜的火蓝刀锋
来源:新华网 | 2022-03-30 10:27:28

↑特战队员进行重机枪射击训练。杨捷 摄
云飞浪卷,碧波万顷。仲春时节,中国海军第40批护航编队骆马湖舰上,几个身影敏捷地在狭窄的通道内穿梭。一场实战化营救训练,正在紧张进行。
“你部1名队员受伤,请立刻救治!”
“你行进路线前方发现明火,迅速调整行动!”
接踵而至的导调情节,让突击组组长范如华高度紧张。即便是第5次执行护航任务,经验丰富的他也丝毫不敢掉以轻心。
经过一番搜索与“战斗”,范如华带领他的小队找到了模拟安全舱,成功“解救”出“被困船员”。
负责组织训练的连长宁国顺表示,在此次训练中,他们结合骆马湖舰舱室多、内部结构复杂等特点,采取“1+N”模式,穿插多种特情,“拼图式”组织多类课目同步训练,以此考验特战队员日常训练水平和应急处突能力。
作为特战分队中最年轻的重机枪手,赵德远渴望在远海大洋上锤炼本领、提升作战能力。然而,走上战位,架好机枪,上好子弹,赵德远却有点摸不着头脑——湛蓝的大海上没有设置任何标靶。
“前方500米,对可疑目标实施横向拦阻射击!”
随着现场指挥员的一声令下,赵德远迅速转动固定栓,调整射击角度,扣动扳机。茫茫大海上,数道水柱应声而起。几轮射击过后,赵德远已是大汗淋漓。
训练结束后,赵德远坦言,这种听令射击的训练方式,给他带来了很大的心理压力,但是也可以帮助他快速成长。
“应急处突,练的就是心理稳、反应快、下手准。”训练结束后,特战分队队长姬庆说,海上“近身搏击”事发突然,决策时间短,进入战斗快,这就要求官兵拥有过硬的军事素养、反应能力和心理素质,“如果没有一颗强大的心脏,做不到该出手时果断出手,那么可能就会出现失误”。
“格斗训练可以安排在更狭小的空间内进行……”当天夜里,编队呼和浩特舰会议室内灯火通明,桌上的训练教材被一一翻开,电脑显示屏上播放着训练视频。姬庆和几名分队长围坐在一起,商定下一次的训练方案。
编队护航责任重大,练兵备战刻不容缓。为了紧贴实战,他们立足于破解难局、盘活残局、扭转危局,把对手假想得更强大、把环境布置得更多元、把情节设置得更复杂,坚持航行一路、训练一路、提高一路,不断锤炼打赢本领,在亚丁湾上磨砺敢打必胜的火蓝刀锋。(杨捷、邱远毅)
编辑: 梁华
分享: